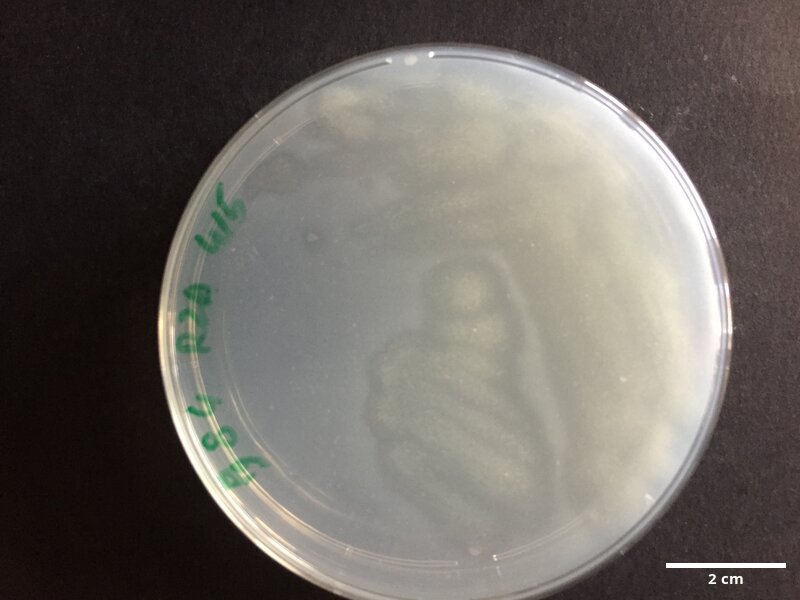
Uncultured_Tenacibaculum_sp_cloneC114001147_CCMAR-S_PG84

Classification – Phylum: Bacteroidetes Class: Flavobacteria Order: Flavobacteriales Family: Flavobacteriaceae Genus: Tenacibaculum Species: Tenacibaculum sp.
| Sampling Date | 30/04/2021 |
| Sampling site (Continent, Country, Site) | Europe, Portugal, Ramalhete Station (Faro) |
| Latitude / longitude | 37.00682° / -7.96735° |
| Environment | Marine |
| Depth | N/A |
| Sampler | Joana Filipe |
| Isolator | Joana Filipe |
| Isolation year | 30/04/2021 |
| Host species | Paramuricea grayi (yellow variety) |
| Sample status | Clonal, aerobic, non-axenic |
| Culture conditions | Temperature (ºC): − 80 |
| Genetic information | Barcoding |
| GMO | No |
| Pathogen | Unknown |
| Toxin producer | Not toxic |
| Taxonomy WoRMS ID | – |
| Notes | Microbiome sampled from coral in culture in Ramalhete station (Faro) |